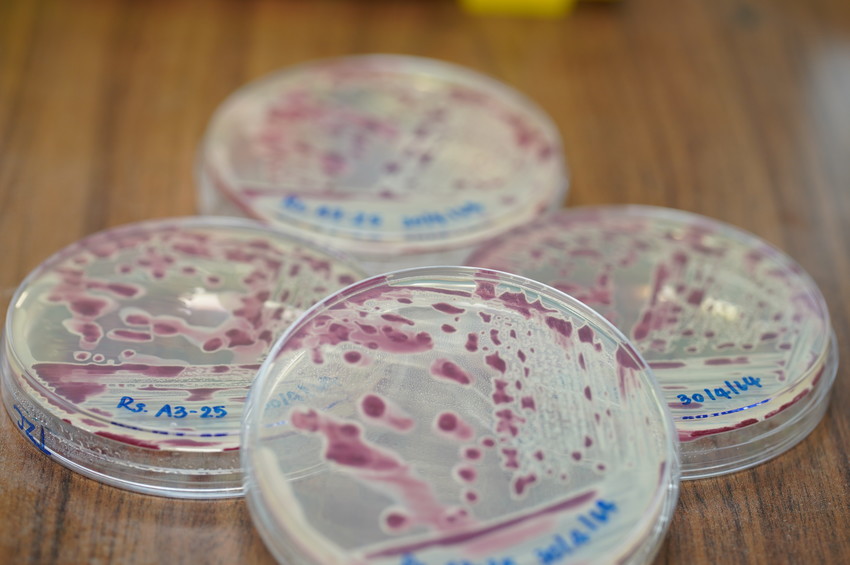

โดย ศูนย์พันธุวิศวกรรมและเทคโนโลยีชีวภาพแห่งชาติ (ไบโอเทค) ได้ศึกษาและพัฒนา แบคทีรีโอฟาจ (bacteriophage) หรือ ฟาจ (phage) ซึ่งเป็นไวรัสที่มีประสิทธิภาพในการเข้าทำลายเชื้อแบคทีเรียก่อให้เกิดโรคในพืช เพื่อใช้เป็นสารชีวภัณฑ์ในการกำจัดเชื้อแบคทีเรียสาเหตุโรคพืช ทดแทนการใช้สารเคมี เพื่อความปลอดภัยต่อเกษตรกรและผู้บริโภค มุ่งเป้าพัฒนาสูตการเก็บรักษาฟาจให้คงทนต่อสภาพแวดล้อม เพื่อนำไปใช้จริงในพื้นที่เกษตรกรรม โรคเหี่ยวเขียวหรือโรคเหี่ยว (bacterial wilt disease) มีสาเหตุมาจากเชื้อแบคทีเรีย ราลสโตเนีย โซลานาซีเอรัม (Ralstonia solanacearum) จัดเป็นเชื้อแบคทีเรียสาเหตุโรคพืชที่มีความสำคัญมากชนิดหนึ่ง ซึ่งทำให้เกิดโรคเหี่ยวกับพืชมากกว่า 200 ชนิด โดยเฉพาะพืชเศรษฐกิจสำคัญ เช่น มะเขือเทศ มะเขือ มันฝรั่ง พริก พริกไทย กล้วย ขิง ถั่วลิสง และยาสูบ เป็นต้น โดยจากสถิติขององค์การอาหารและเกษตรแห่งสหประชาชาติ (FAO) โรคเหี่ยวเขียวสร้างความเสียหายเป็นมูลค่ากว่า 35,000 ล้านบาททั่วโลก สำหรับในประเทศไทยพบว่าโรคเหี่ยวเขียวสร้างความเสียหายให้กับผลผลิตมะเขือเทศและพริกคิดเป็นมูลค่ารวมกว่า 540 ล้านบาทต่อปี เชื้อแบคทีเรียราลสโตเนีย โซลานาซีเอรัม ซึ่งเป็นสาเหตุของโรคสามารถอาศัยอยู่ในดิน โดยจะเข้าทำลายพืชทางราก ตามรอยแผลที่เกิดจากการทำลายของแมลง ไส้เดือนฝอย รอยฉีกขาดของราก หรือแผลที่เกิดในธรรมชาติ และสามารถแพร่ระบาดไปกับน้ำได้ดีโดยเฉพาะในช่วงฤดูฝนที่มีฝนตกชุกจะมีการระบาดของโรครุนแรงและรวดเร็ว รวมทั้งเชื้อแบคทีเรียนี้สามารถติดไปกับหัวพันธุ์โดยแอบแฝงอยู่ในหัวพันธุ์และอยู่ข้ามฤดูได้ การป้องกันกำจัดทำได้ค่อนข้างยาก เนื่องจากเชื้อสามารถอยู่ในดินได้เป็นเวลานาน ทั้งยังมีพืชอาศัยกว้าง และมีความหลากหลายของสายพันธุ์ ปัจจุบันยังไม่มีสารเคมีที่มีประสิทธิภาพสูงในการป้องกันกำจัด ทำให้เชื้อแบคทีเรียนี้ปัญหาที่สำคัญอย่างหนึ่งในแหล่งปลูกมะเขือเทศและพริกทั่วประเทศ นับได้ว่าส่งผลกระทบต่อพืชเศรษฐกิจของไทยเป็นอย่างมาก
ดร.อุดม แซ่อึ่ง นักวิจัย ทีมวิจัยการวิเคราะห์และประยุกต์ใช้สารชีวโมเลกุล ไบโอเทค ให้ข้อมูลว่า การป้องกันและควบคุมโรคเหี่ยวในปัจจุบันทำได้โดยการทำเขตกรรม เช่น การไถดินและผึ่งดินให้แห้งก่อนการปลูก การปรับสภาพดินด้วยปูนขาว การกำจัดต้นพืชที่แสดงอาการ เป็นต้น ซึ่งการใช้สารเคมีเพื่อกำจัดเชื้อแบคทีเรียยังไม่มีประสิทธิภาพมากนัก เนื่องจากสารเคมีไม่สามารถเข้าถึงเชื้อแบคทีเรียที่อาศัยอยู่ในดินได้ ดังนั้นทางเลือกหนึ่งในการป้องกันและควบคุมโรคเหี่ยวได้ดี คือการใช้แบคทีรีโอฟาจ (bacteriophage) ซึ่งสามารถเข้าทำลายและย่อยสลาย (lysis) แบคทีเรียก่อโรคพืชได้โดยตรง นับเป็นทางเลือกหนึ่งที่มีศักยภาพสูง ในการป้องกันและควบคุมโรคพืชหลากหลายชนิดรวมทั้งโรคเหี่ยวด้วย
ดร.อุดม ให้ข้อมูลเพิ่มเติมว่า จากการศึกษาร่วมกับ ดร.อรวรรณ ชัชวาลการพาณิชย์ และทีมวิจัยไวรัสพืชและแบคทีรีโอฟาจ ไบโอเทค พบว่า คุณสมบัติที่สำคัญของแบคทีรีโอฟาจ ซึ่งเหมาะกับการนำมาใช้ควบคุมแบคทีเรียที่ก่อให้เกิดโรคในพืช คือ แบคทีรีโอฟาจ มีความเฉพาะเจาะจงกับแบคทีเรียแต่ละชนิด (specificity) โดยแบคทีรีโอฟาจจะไม่ทำลายแบคทีเรียที่ไม่ใช่เป้าหมาย ซึ่งหมายความว่า แบคทีรีโอฟาจที่พัฒนาขึ้นนี้จะไม่ทำลายแบคทีเรียชนิดอื่นๆ โดยเฉพาะแบคทีเรียที่เป็นประโยชน์ที่อยู่ตามธรรมชาติ และแบคทีรีโอฟาจจะหยุดเพิ่มจำนวนทันที เมื่อเชื้อแบคทีเรียเป้าหมายหมดไป แบคทีรีโอฟาจไม่เป็นพิษต่อพืช สัตว์และสิ่งแวดล้อม จึงเป็นทางเลือกสำหรับการเกษตรแบบยั่งยืนและเป็นมิตรกับสิ่งแวดล้อม

อย่างไรก็ตาม การใช้แบคทีรีโอฟาจยังคงมีอุปสรรคและปัญหาสำคัญ คือ ความคงทนของแบคทีรีโอฟาจ (phage stability) เมื่อฟาจต้องเจอกับการเปลี่ยนแปลงของปัจจัยภายนอกในสิ่งแวดล้อม เช่น อุณหภูมิ ความเป็นกรดด่าง สภาพเกลือในดิน เป็นต้น โครงสร้างของแบคทีรีโอฟาจอันประกอบด้วยโปรตีนและดีเอ็นเอ จึงแตกสลายได้ง่าย (degradation) จึงจำเป็นต้องมีการแก้ไขปัญหาความคงทนของแบคทีรีโอฟาจ โดยใช้งานวิจัยและเทคโนโลยีทั้งทางชีววิทยา เคมีและฟิสิกส์ อาทิ การศึกษาโครงสร้างของแบคทีรีโอฟาจในสภาวะต่างๆ การศึกษาความแข็งแรงเชิงโครงสร้างของแบคทีรีโอฟาจ การศึกษากลไกการเข้าทำลายเชื้อแบคทีเรียของแบคทีรีโอฟาจ เป็นต้น เพื่อสร้างองค์ความรู้ด้านความคงทนของแบคทีรีโอฟาจ และปัจจัยต่างๆ ที่มีผล โดยองค์ความรู้นี้สามารถนำไปประยุกต์ใช้พัฒนาความคงทนของแบคทีรีโอฟาจให้สูงขึ้น ซึ่งจะมีประโยชน์ต่อการเก็บรักษาแบคทีรีโอฟาจ (storage) เช่น สูตรการเก็บรักษา (storage formulation) และการนำแบคทีรีโอฟาจไปใช้งานจริงในพื้นที่เกษตรกรรม (field utilization) ต่อไปในอนาคต



















